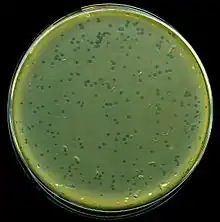

Phage typing
Phage typing is a phenotypic method that uses bacteriophages ("phages" for short) for detecting and identifying single strains of bacteria.[1] Phages are viruses that infect bacteria and may lead to bacterial cell lysis.[2] The bacterial strain is assigned a type based on its lysis pattern.[3] Phage typing was used to trace the source of infectious outbreaks throughout the 1900s, but it has been replaced by genotypic methods such as whole genome sequencing for epidemiological characterization.[1]
Principle
Phage typing is based on the specific binding of phages to antigens and receptors on the surface of bacteria and the resulting bacterial lysis or lack thereof.[4] The binding process is known as adsorption.[5] Once a phage adsorbs to the surface of a bacteria, it may undergo either the lytic cycle or the lysogenic cycle.[6]
Virulent phages enter the lytic cycle where they replicate and lyse the bacterial cell.[7] Virulent phages can differentiate between different species of bacteria based on their specific lytic action.[8] Lysis will only occur if the virulent phage adsorbs to the bacterial surface, configuring species specificity to phages.[5]
Temperate phages enter the lysogenic cycle and do not immediately lyse the cell.[7] The phage is instead integrated into the bacterial genome as a prophage during lysogenization, which protects the cell from being lysed by phages which are serologically identical or related.[9] Since it is incorporated into the genome, the prophage is also passed down to the bacteria's progenies.[7] The bacterial strain carrying the prophage is known as a lysogenic strain.[9] Lysogenization is strain-specific, so it allows for differentiation among different strains of bacteria within the same species.[10] The prophage may be chemically or physically induced to revert to the lytic pathway.[6]
Method
The bacterial strain to be characterized is cultured on an agar Petri dish and dried.[11] Once dry, a grid or another recognizable pattern is drawn on the base to mark out different regions.[11] Each region is inoculated with a different phage at its routine test dilution and then incubated for 5-48 hours.[11] The susceptible phage regions will display a clearing where the bacteria have been lysed, and this is used in differentiation.[12] The size, morphology, and pattern of the lysed region are important criteria for differentiating bacterial species and strains.[13] They are compared against a standard scheme of lysis patterns to assign a type to the strain.[14]
Routine Test Dilution (RTD)
Routine test dilution (RTD) is typically defined as the lowest phage dilution that still yields lysis of its host.[11] This technique prevents a phenomenon known as "lysis from without", which is bacterial lysis induced by high multiplicity phage adsorption rather than phage replication.[15]
History
The first reported use of bacteriophages to identify bacteria was in 1925 when Sonnenschein used typhoid and paratyphoid phages to diagnose typhoid.[16] In 1934, it was discovered that some strains of Salmonella typhi displayed Vi antigens on the surface.[17] This led to the isolation of Vi phages capable of lysing typhoid bacteria strains but only if they displayed the Vi antigen[18] enabling the differentiation of typhoid species expressing the Vi antigen and those which do not.
In 1938, Craigie and Yen adapted Vi phages by selective propagation and used them at their critical test dilutions to differentiate 11 types of B. typhosus.[19] In 1943, Felix and Callow extended the method to Salmonella paratyphi B. in 1943 and differentiated 12 types with 11 phages.[20] The International Committee for Enteric Phage Typing was established in 1947, and these phage typing methods were soon standardized.[21]
Improvements to the specificity of phage typing schemes were made throughout the next few decades. In 1959, Callow improved her initial scheme to differentiate 34 types of Salmonella typhimurium with 29 phages.[22] In 1977, this was extended to 207 types by Anderson at the Enteric Reference Laboratory in London.[22] Since then, phage typing schemes have been developed for Salmonella typhi, Salmonella paratyphi B., Salmonella typhimurium, Shigella sonnei, Staphylococcus aureus, and Escherichia coli to name a few.[23][24]
Limitations
Phage typing requires the use of a comprehensive number of phages, so it is typically only used in reference laboratories.[25] It also relies on the interpretation of the individual lysis pattern and comparison to a standard which has led to conflicting results from different laboratories in the past.[26] Furthermore, bacteriophages mutate so reference phages must be maintained.[25]
Phage Isolation
Phages used for phage typing are generally isolated from the native habitats of the host bacterial strain.[27] These may include sewage, feces, soil, and water.[27] Temperate phages may be isolated from the bacterium itself since it is incorporated into the bacterial genome during lysogenization.[27]
References
- 1 2 Baggesen DL, Sørensen G, Nielsen EM, Wegener HC (2010). "Phage typing of Salmonella Typhimurium - is it still a useful tool for surveillance and outbreak investigation?". Eurosurveillance. 15 (4): 19471. doi:10.2807/ese.15.04.19471-en. PMID 20122382.
{{cite journal}}: CS1 maint: multiple names: authors list (link) - ↑ "bacteriophage | Definition, Life Cycle, & Research | Britannica". www.britannica.com. Retrieved 2021-11-20.
- ↑ "Encyclopedia of Virology | ScienceDirect". www.sciencedirect.com. Retrieved 2021-11-15.
- ↑ Felix, A.; Callow, B. R. (1943-07-31). "Typing of Paratyphoid B Bacilli by Vi Bacteriophage". British Medical Journal. 2 (4308): 127–130. doi:10.1136/bmj.2.4308.127. ISSN 0007-1447. PMC 2284669. PMID 20784954.
- 1 2 Bertozzi Silva, Juliano; Storms, Zachary; Sauvageau, Dominic (2016-02-01). "Host receptors for bacteriophage adsorption". FEMS Microbiology Letters. 363 (4): fnw002. doi:10.1093/femsle/fnw002. ISSN 0378-1097. PMID 26755501.
- 1 2 Kropinski, Andrew M (2006). "Phage Therapy – Everything Old is New Again". The Canadian Journal of Infectious Diseases & Medical Microbiology. 17 (5): 297–306. doi:10.1155/2006/329465. ISSN 1712-9532. PMC 2095089. PMID 18382643.
- 1 2 3 "21.2B: The Lytic and Lysogenic Cycles of Bacteriophages". Biology LibreTexts. 2018-07-14. Retrieved 2021-10-31.
- ↑ Koskella, Britt; Meaden, Sean (2013-03-11). "Understanding bacteriophage specificity in natural microbial communities". Viruses. 5 (3): 806–823. doi:10.3390/v5030806. ISSN 1999-4915. PMC 3705297. PMID 23478639.
- 1 2 Boyd, J. S. K. (1956-07-21). "Immunity of Lysogenic Bacteria". Nature. 178 (4525): 141. Bibcode:1956Natur.178..141B. doi:10.1038/178141a0. ISSN 1476-4687. PMID 13348647. S2CID 4162932.
- ↑ "Encyclopedia of Virology | ScienceDirect". www.sciencedirect.com. Retrieved 2021-11-15.
- 1 2 3 4 "Encyclopedia of Virology | ScienceDirect". www.sciencedirect.com. Retrieved 2021-11-15.
- ↑ Turbadkar SD, Ghadge DP, Patil S, Chowdhary AS, Bharadwaj R (April 2007). "Circulating phage type of Vibrio cholerae in Mumbai". Indian Journal of Medical Microbiology. 25 (2): 177–8. doi:10.4103/0255-0857.49436. hdl:1807/53709. PMID 17582202.
- ↑ Schofield, David A.; Sharp, Natasha J.; Westwater, Caroline (2012-04-01). "Phage-based platforms for the clinical detection of human bacterial pathogens". Bacteriophage. 2 (2): 105–283. doi:10.4161/bact.19274. ISSN 2159-7073. PMC 3442824. PMID 23050221.
- ↑ Baggesen DL, Sørensen G, Nielsen EM, Wegener HC (2010). "Phage typing of Salmonella Typhimurium - is it still a useful tool for surveillance and outbreak investigation?". Eurosurveillance. 15 (4): 19471. doi:10.2807/ese.15.04.19471-en. PMID 20122382.
{{cite journal}}: CS1 maint: multiple names: authors list (link) - ↑ Abedon, Stephen T (2011). "Lysis from without". Bacteriophage. 1 (1): 46–49. doi:10.4161/bact.1.1.13980. ISSN 2159-7073. PMC 3109453. PMID 21687534.
- ↑ Brandis, Henning (1957), Kikuth, W.; Meyer, K. F.; Nauck, E. G.; Pappenheimer, A. M. (eds.), "Die Anwendung von Phagen in der bakteriologischen Diagnostik mit besonderer Berücksichtigung der Typisierung von Typhus- und Paratyphus B-Bakterien sowie Staphylokokken", Ergebnisse der Mikrobiologie, Immunitätsforschung und experimentellen Therapie: Fortsetzung der Ergebnisse der Hygiene, Bakteriologie, Immunitätsforschung und experimentellen Therapie (in German), Berlin, Heidelberg: Springer, pp. 96–159, doi:10.1007/978-3-662-25832-3_3, ISBN 978-3-662-25832-3, retrieved 2021-11-15
- ↑ Robertson, R. C.; Yu, H. (1936). "The Vi antigen of B. typhosus". The Journal of Pathology and Bacteriology. 43 (1): 191–196. doi:10.1002/path.1700430120. ISSN 1555-2039.
- ↑ Scholtens, R. Th. (1937). "Adsorption of vi Bacteriophages by Typhoid Bacilli and Paratyphoid C Strains". The Journal of Hygiene. 37 (2): 315–317. doi:10.1017/S0022172400035026. ISSN 0022-1724. JSTOR 3859853. PMC 2199419. PMID 20475383.
- ↑ CRAIGIE, JAMES; YEN, CHUN HUI (1938). "The Demonstration of Types of B. Typhosus by Means of Preparations of Type II Vi Phage: I. Principles and Technique". Canadian Public Health Journal. 29 (9): 448–463. ISSN 0319-2652. JSTOR 41977832.
- ↑ Felix, A.; Callow, B. R. (1943-07-31). "Typing of Paratyphoid B Bacilli by Vi Bacteriophage". British Medical Journal. 2 (4308): 127–130. doi:10.1136/bmj.2.4308.127. ISSN 0007-1447. PMC 2284669. PMID 20784954.
- ↑ "International Federation for Enteric Phage Typing | UIA Yearbook Profile | Union of International Associations". uia.org. Retrieved 2021-11-15.
- 1 2 Anderson, E. S.; Ward, Linda R.; de Saxe, Maureen J.; de Sa, J. D. H. (1977). "Bacteriophage-Typing Designations of Salmonella typhimurium". The Journal of Hygiene. 78 (2): 297–300. doi:10.1017/S0022172400056187. ISSN 0022-1724. JSTOR 3861882. PMC 2129838. PMID 321679.
- ↑ Anderson, E. S.; Williams, R. E. (May 1, 1956). "Bacteriophage typing of enteric pathogens and staphylococci and its use in epidemiology". Journal of Clinical Pathology. 9 (2): 94–127. doi:10.1136/jcp.9.2.94. ISSN 0021-9746. PMC 1023924. PMID 13332068.
- ↑ Gershman, M.; Merrill, Cynthia E.; Hunter, Jacqueline (1981-12-01). "Phage Typing Set for Differentiating Escherichia coli". Journal of Dairy Science. 64 (12): 2392–2400. doi:10.3168/jds.S0022-0302(81)82862-7. ISSN 0022-0302. PMID 7042781.
- 1 2 "Phage Typing Method: Principle, Procedure, Results • Microbe Online". Microbe Online. 2020-03-05. Retrieved 2021-11-20.
- ↑ Baggesen DL, Sørensen G, Nielsen EM, Wegener HC (2010). "Phage typing of Salmonella Typhimurium - is it still a useful tool for surveillance and outbreak investigation?". Eurosurveillance. 15 (4): 19471. doi:10.2807/ese.15.04.19471-en. PMID 20122382.
{{cite journal}}: CS1 maint: multiple names: authors list (link) - 1 2 3 "Encyclopedia of Virology | ScienceDirect". www.sciencedirect.com. Retrieved 2021-11-15.